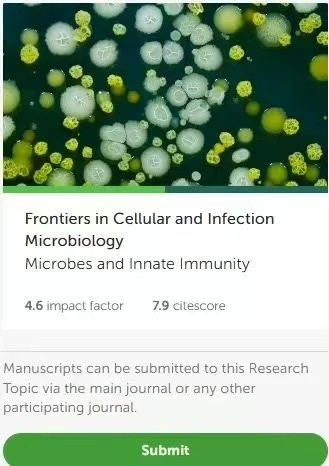
Saleem Ahmad

Saleem Ahmad/LinkedIn
Oct 12, 2025, 07:56
Saleem Ahmad: Call for Papers on Innate Reproductive Immunology
Saleem Ahmad, Postdoctoral Scientist at University of Kansas Medical Center, shared a post on LinkedIn:
“Call for Papers: Innate Reproductive Immunology and Microbial Recognition Mechanisms
Attention Researchers and Authors!
We’re excited to invite submissions for our Special Research Topic: ‘Innate Reproductive Immunology and Microbial Recognition Mechanisms in Mammalian Reproductive Systems.’
Focus Areas:
- Immune tolerance in pregnancy
- Microbiota and female reproductive immunity
- Antimicrobial peptides in reproduction
- Innate immunity in ART and reproductive infections
Key Deadlines:
- Manuscript Summary Submission: August 14, 2025
- Full Manuscript Submission: December 2, 2025.”
-
Oct 11, 2025, 06:44The Global IVF Market Is Set to Reach $65B by 2032 – Meddilink
-
Nov 6, 2025, 12:13Marco Zaccaria: Next LejEndo Dives Into ICG Innovation in Surgery
-
Nov 6, 2025, 12:04Silvia Alvarez: Do Endometriosis or Adenomyosis Affect Oocyte Quality and Pregnancy Rates?
-
Nov 6, 2025, 11:59Mary Mulcahey: Culture Eats Strategy and Grit Fuels Growth
-
Nov 6, 2025, 11:46Connection Between Infertility Treatments and Stroke Risk – Reproduction and Fertility
-
Nov 6, 2025, 00:03Fertility and Sterility: Special Issue Explores Human Embryo Testing and Phased Validation
-
Nov 5, 2025, 23:51William Wallace: How Your Gut Microbes Help Set Your Body’s Internal Clock
-
Nov 5, 2025, 13:34Nibhash Kumar: When Embryos Stop Growing and the Hidden Reasons Behind Early Developmental Arrest
-
Nov 5, 2025, 13:29Ahsan Saeed: DNA From Three Parents Just Stopped a Life-Threatening Disorder Before Birth!
-
Nov 5, 2025, 13:24New Weighted Classification Criteria Refine Antiphospholipid Syndrome Research – Hæmatologi DK
